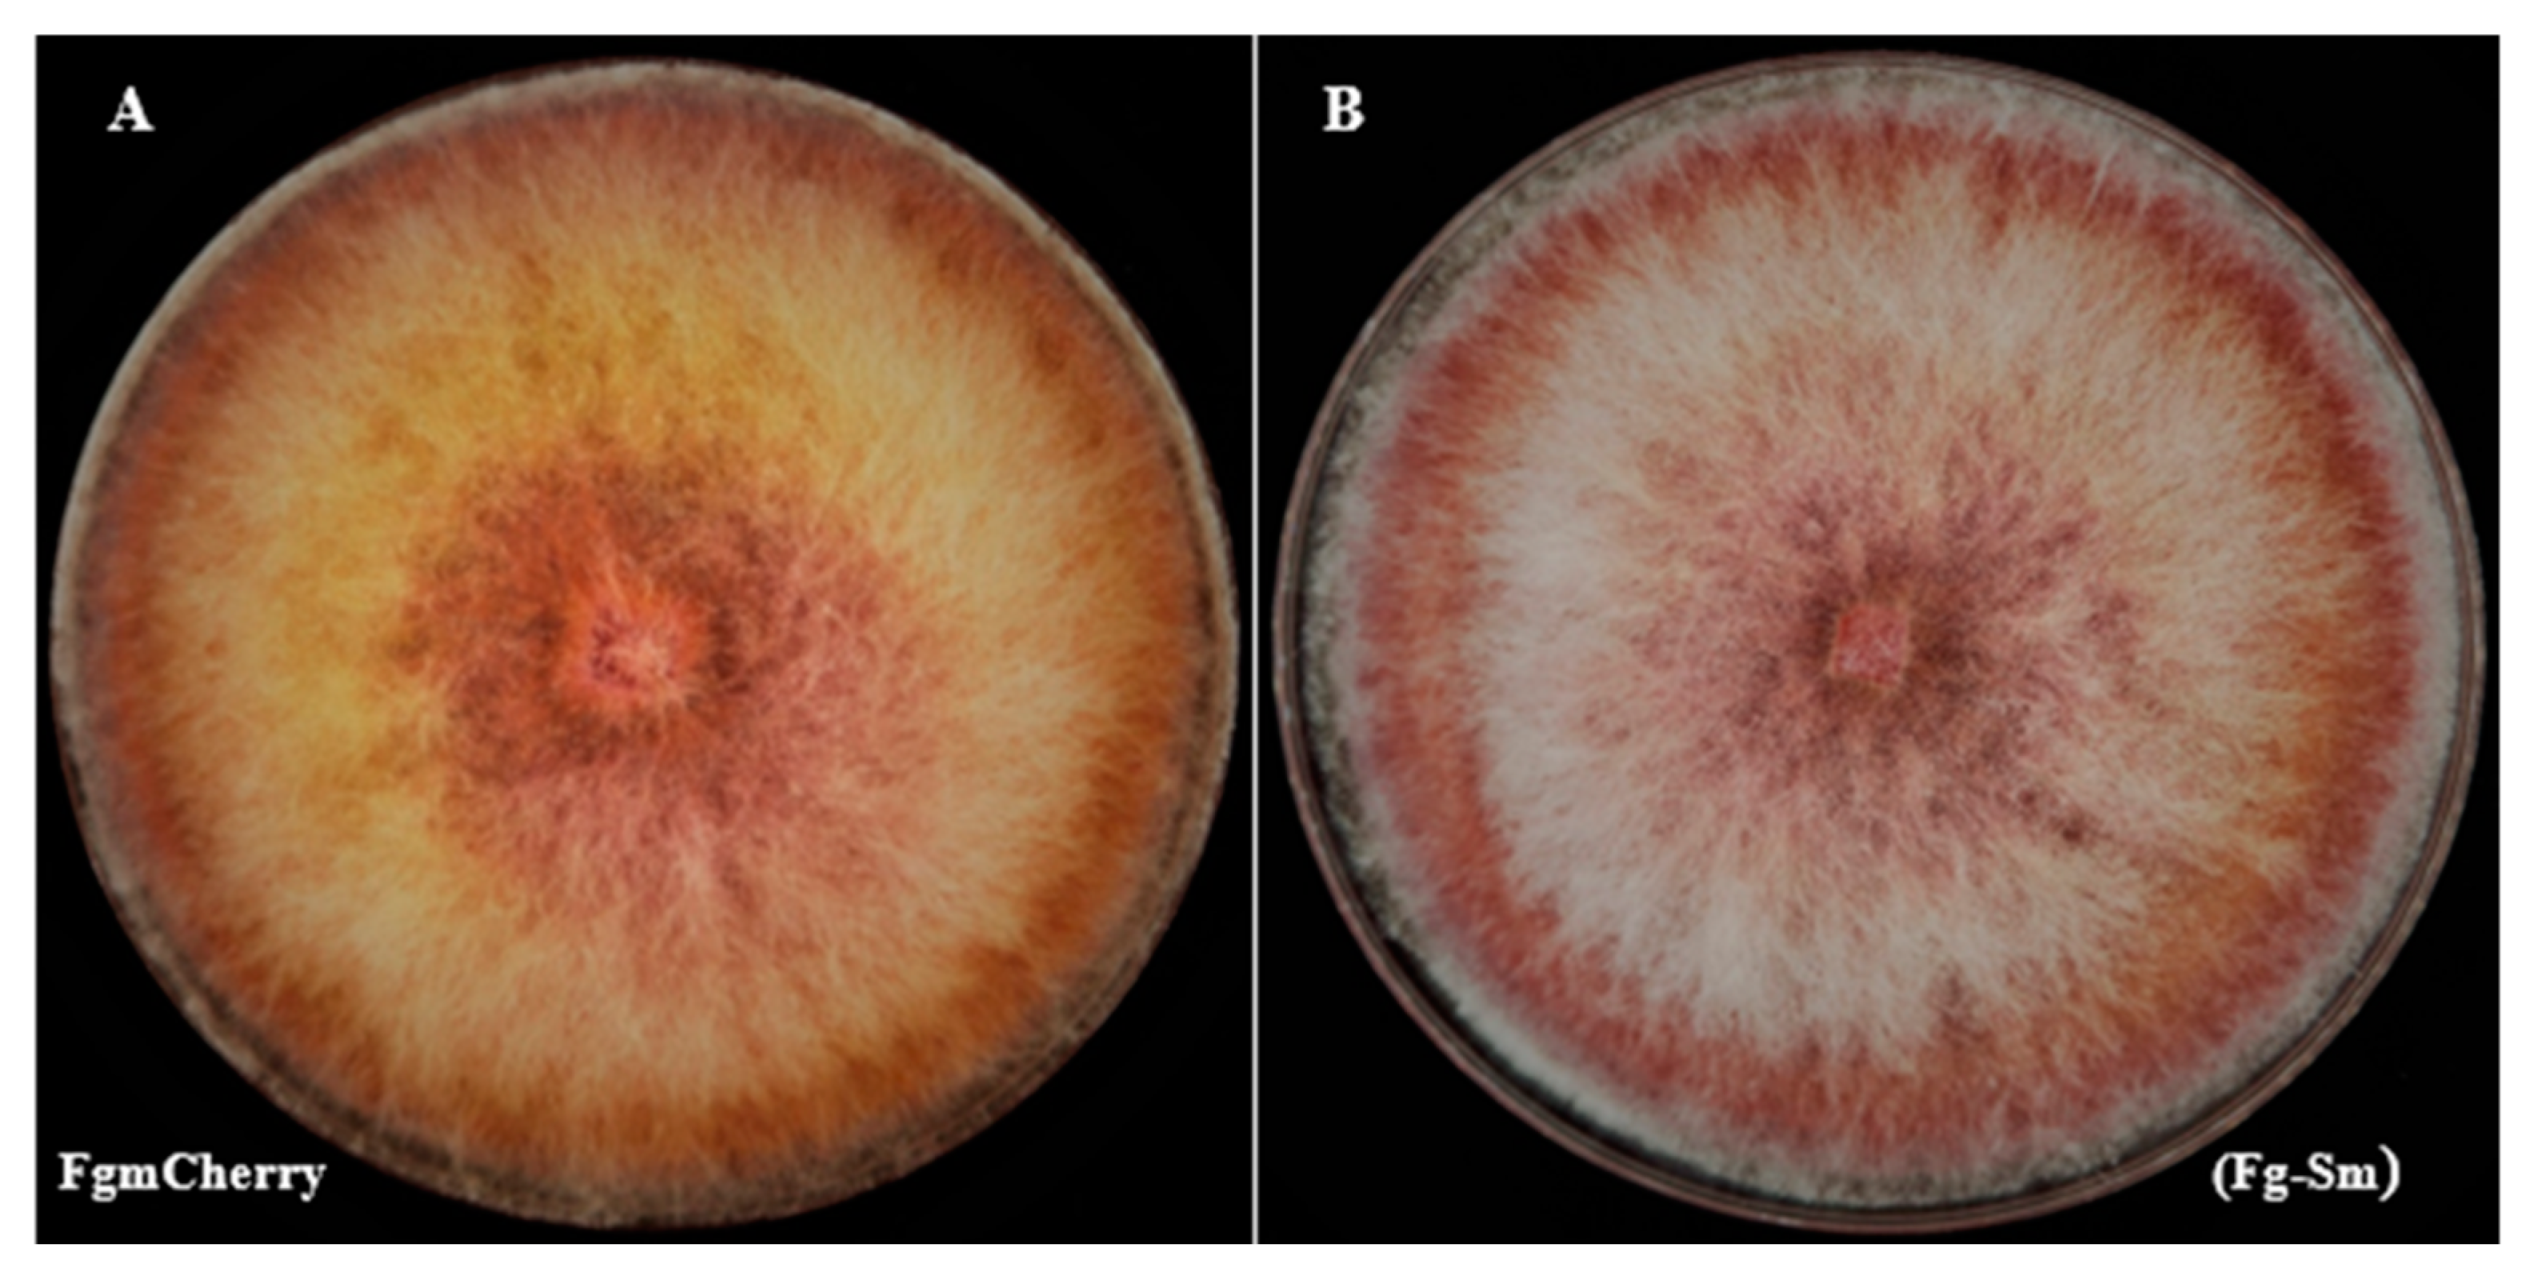
Cells 11 03004 g003 Cells 11 03004 g003

The Wheat Head Blight Pathogen Fusarium graminearum Can Recruit Collaborating Bacteria from Soil
Abstract
1. Introduction
2. Materials and Methods
2.1. Fungal Strains, Culture, and Growth Conditions
2.2. Construction of Reporter Strain and Validation of (FgHis1mCherry) as Reporter Strain
2.3. Development of an Isolation Method to Catch FEB Using a Fungal Highway Column Technique
2.4. Isolation and Purification of Fg-FEB
2.5. Molecular Analysis of the Presence of FEB in the Potential Fg-FEB Cultures Using 16SrRNA Gene Sequencing
2.6. Comparison of Fg-FEB Colony Phenotypes with FgHis1mCherry
2.7. qPCR of FgFEBrRNA/His1mCHERRY to Estimate Bacterial Load in the Fungus
2.8. Pathogenicity Assay of Fg-S. Maltophilia and PH-1 Used in Labs and Estimation of Fungal Bacterial Load during Wheat Coleoptile Infection
2.9. Testing Nitrogen-Fixing Capability of Fg-S. Maltophilia vs. PH-1 and Testing the Nitrogen-Fixing Ability by Comparing Protein Content of Cultures
2.10. Statistics and Statistical Considerations
3. Results
3.1. Validation of the FgHis1mCherry Reporter Strain
3.2. Isolation and Purification of Fg-FEB Holobionts
3.3. Molecular Detection of FEB Inside the FgHis1mCherry Reporter Strain
3.4. Effect of FEB on FgHis1mCherry Colony Morphology on Standard Media
3.5. Stability of Fg-S. maltophilia and Estimation of Bacterial Load of the Fungus
3.6. Pathogenicity of Fg-S. maltophilia v/s PH-1
3.7. Estimation of FEB Load in Fg-S. altophilia in Culture Conidia/Mycelium in Infected Plants
3.8. Nitrogen Fixation Capability of the Fg-S. maltophilia Holobiont
3.9. Microscopy of the Fg-S. maltophilia Holobiont
4. Discussion
Supplementary Materials
Author Contributions
Funding
Institutional Review Board Statement
Informed Consent Statement
Data Availability Statement
Acknowledgments
Conflicts of Interest
References
- Jochum, C.C.; Osborne, L.E.; Yuen, G.Y. Fusarium Head Blight Biological Control with Lysobacter Enzymogenes Strain C3. Biol. Control 2006, 39, 336–344. [Google Scholar] [CrossRef]
- Cuong, N.D.; Nicolaisen, M.H.; Sørensen, J.; Olsson, S. Hyphae-Colonizing Burkholderia Sp.—A New Source of Biological Control Agents against Sheath Blight Disease (Rhizoctonia Solani AG1-IA) in Rice. Microb. Ecol. 2011, 62, 425–434. [Google Scholar] [CrossRef] [PubMed]
- Christiansen, L.; Alanin, K.S.; Phippen, C.B.W.; Olsson, S.; Stougaard, P.; Hennessy, R.C. Fungal-Associated Molecules Induce Key Genes Involved in the Biosynthesis of the Antifungal Secondary Metabolites Nunamycin and Nunapeptin in the Biocontrol Strain Pseudomonas Fluorescens In5. Appl. Environ. Microbiol. 2020, 86, e01284-20. [Google Scholar] [CrossRef] [PubMed]
- Frey-Klett, P.; Burlinson, P.; Deveau, A.; Barret, M.; Tarkka, M.; Sarniguet, A. Bacterial-Fungal Interactions: Hyphens between Agricultural, Clinical, Environmental, and Food Microbiologists. Microbiol. Mol. Biol. Rev. 2011, 75, 583–609. [Google Scholar] [CrossRef] [PubMed]
- Olsson, S.; Bonfante, P.; Pawlowska, T.E. Ecology and Evolution of Fungal-Bacterial Interactions. In The Fungal Community: Its Organization and Role in the Ecosystem; Dighton, J., White, J.F., Eds.; CRC Press: Boca Raton, FL, USA, 2017; ISBN 9781498706650. [Google Scholar]
- Deveau, A.; Bonito, G.; Uehling, J.; Paoletti, M.; Becker, M.; Bindschedler, S.; Hacquard, S.; Hervé, V.; Labbé, J.; Lastovetsky, O.A.; et al. Bacterial–Fungal Interactions: Ecology, Mechanisms and Challenges. FEMS Microbiol. Rev. 2018, 42, 335–352. [Google Scholar] [CrossRef]
- Junier, P.; Cailleau, G.; Palmieri, I.; Vallotton, C.; Trautschold, C.; Junier, T.; Paul, C.; Bregnard, D.; Palmieri, F.; Estoppey, A.; et al. Democratization of Fungal Highway Columns as a Tool to Investigate Bacteria Associated with Soil Fungi. FEMS Microbiol. Ecol. 2021, 97, 15. [Google Scholar] [CrossRef]
- Yakop, F.; Taha, H.; Shivanand, P. Isolation of Fungi from Various Habitats and Their Possible Bioremediation. Curr. Sci. 2019, 116, 733. [Google Scholar] [CrossRef]
- Hoffman, M.T.; Arnold, A.E. Diverse Bacteria Inhabit Living Hyphae of Phylogenetically Diverse Fungal Endophytes. Appl. Environ. Microbiol. 2010, 76, 4063–4075. [Google Scholar] [CrossRef]
- Rodriguez, R.J.; White, J.F., Jr.; Arnold, A.E.; Redman, R.S. Fungal Endophytes: Diversity and Functional Roles. New Phytol. 2009, 182, 314–330. [Google Scholar] [CrossRef]
- Lofgren, L.A.; LeBlanc, N.R.; Certano, A.K.; Nachtigall, J.; LaBine, K.M.; Riddle, J.; Broz, K.; Dong, Y.; Bethan, B.; Kafer, C.W.; et al. Fusarium Graminearum: Pathogen or Endophyte of North American Grasses? New Phytol. 2018, 217, 1203–1212. [Google Scholar] [CrossRef]
- Ghignone, S.; Salvioli, A.; Anca, I.; Lumini, E.; Ortu, G.; Petiti, L.; Cruveiller, S.; Bianciotto, V.; Piffanelli, P.; Lanfranco, L.; et al. The Genome of the Obligate Endobacterium of an AM Fungus Reveals an Interphylum Network of Nutritional Interactions. ISME J. 2012, 6, 136–145. [Google Scholar] [CrossRef] [PubMed]
- Mondo, S.J.; Toomer, K.H.; Morton, J.B.; Lekberg, Y.; Pawlowska, T.E. Evolutionary Stability In A 400-Million-Year-Old Heritable Facultative Mutualism: Evolution In Glomeromycota-Glomeribacter Symbiosis. Evolution 2012, 66, 2564–2576. [Google Scholar] [CrossRef] [PubMed]
- Hoffman, M.T.; Gunatilaka, M.K.; Wijeratne, K.; Gunatilaka, L.; Arnold, A.E. Endohyphal Bacterium Enhances Production of Indole-3-Acetic Acid by a Foliar Fungal Endophyte. PLoS ONE 2013, 8, e73132. [Google Scholar] [CrossRef]
- Lackner, G.; Moebius, N.; Partida-Martinez, L.; Hertweck, C. Complete Genome Sequence of Burkholderia Rhizoxinica, an Endosymbiont of Rhizopus Microsporus. J. Bacteriol. 2011, 193, 783–784. [Google Scholar] [CrossRef] [PubMed]
- Kohlmeier, S.; Smits, T.H.M.; Ford, R.M.; Keel, C.; Harms, H.; Wick, L.Y. Taking the Fungal Highway: Mobilization of Pollutant-Degrading Bacteria by Fungi. Environ. Sci. Technol. 2005, 39, 4640–4646. [Google Scholar] [CrossRef]
- Simon, A.; Bindschedler, S.; Job, D.; Wick, L.Y.; Filippidou, S.; Kooli, W.M.; Verrecchia, E.P.; Junier, P. Exploiting the Fungal Highway: Development of a Novel Tool for the in Situ Isolation of Bacteria Migrating along Fungal Mycelium. FEMS Microbiol. Ecol. 2015, 91, fiv116. [Google Scholar] [CrossRef]
- Simon, A. Highways and Subways: A Story of Fungi and Bacteria in Soils. Ph.D. Thesis, University of Neuchatel, Neuchatel, Switzerland, 2016. [Google Scholar]
- Furuno, S.; Remer, R.; Chatzinotas, A.; Harms, H.; Wick, L.Y. Use of Mycelia as Paths for the Isolation of Contaminant-Degrading Bacteria from Soil: Use of Mycelia as Paths for the Isolation of Bacteria. Microb. Biotechnol. 2012, 5, 142–148. [Google Scholar] [CrossRef]
- Frandsen, R.J.N.; Albertsen, K.S.; Stougaard, P.; Sørensen, J.L.; Nielsen, K.F.; Olsson, S.; Giese, H. Methylenetetrahydrofolate Reductase Activity Is Involved in the Plasma Membrane Redox System Required for Pigment Biosynthesis in Filamentous Fungi. Eukaryot. Cell 2010, 9, 1225–1235. [Google Scholar] [CrossRef]
- Zhang, L.; Zhang, D.; Chen, Y.; Ye, W.; Lin, Q.; Lu, G.; Ebbole, D.J.; Olsson, S.; Wang, Z. Magnaporthe Oryzae CK2 Accumulates in Nuclei, Nucleoli, at Septal Pores and Forms a Large Ring Structure in Appressoria, and Is Involved in Rice Blast Pathogenesis. Front. Cell. Infect. Microbiol. 2019, 9, 113. [Google Scholar] [CrossRef]
- Baltrus, D.A.; Spraker, J.; Arnold, A.E. Quantifying Re-Association of a Facultative Endohyphal Bacterium with a Filamentous Fungus. In Plant Pathogenic Fungi and Oomycetes; Ma, W., Wolpert, T., Eds.; Methods in Molecular Biology; Springer: New York, NY, USA, 2018; Volume 1848, pp. 1–11. ISBN 978-1-4939-8723-8. [Google Scholar]
- Jia, L.-J.; Wang, W.-Q.; Tang, W.-H. Wheat Coleoptile Inoculation by Fusarium Graminearum for Large-Scale Phenotypic Analysis. Bio-Protocol 2017, 7, e2439. [Google Scholar] [CrossRef]
- Ramos, P.L.; Van Trappen, S.; Thompson, F.L.; Rocha, R.C.S.; Barbosa, H.R.; De Vos, P.; Moreira-Filho, C.A. Screening for Endophytic Nitrogen-Fixing Bacteria in Brazilian Sugar Cane Varieties Used in Organic Farming and Description of Stenotrophomonas Pavanii Sp. Nov. Int. J. Syst. Evol. Microbiol. 2011, 61, 926–931. [Google Scholar] [CrossRef] [PubMed]
- Pillonetto, M.; Arend, L.N.; Faoro, H.; D’Espindula, H.R.S.; Blom, J.; Smits, T.H.M.; Mira, M.T.; Rezzonico, F. Emended Description of the Genus Phytobacter, Its Type Species Phytobacter Diazotrophicus (Zhang 2008) and Description of Phytobacter Ursingii Sp. Nov. Int. J. Syst. Evol. Microbiol. 2018, 68, 176–184. [Google Scholar] [CrossRef] [PubMed]
- Alexander, A.; Singh, V.K.; Mishra, A.; Jha, B. Plant Growth Promoting Rhizobacterium Stenotrophomonas Maltophilia BJ01 Augments Endurance against N2 Starvation by Modulating Physiology and Biochemical Activities of Arachis Hypogea. PLoS ONE 2019, 14, e0222405. [Google Scholar] [CrossRef] [PubMed]
- Singh, R.P.; Jha, P.N. The PGPR Stenotrophomonas Maltophilia SBP-9 Augments Resistance against Biotic and Abiotic Stress in Wheat Plants. Front. Microbiol. 2017, 8, 1945. [Google Scholar] [CrossRef] [PubMed]
- Malz, S.; Grell, M.N.; Thrane, C.; Maier, F.J.; Rosager, P.; Felk, A.; Albertsen, K.S.; Salomon, S.; Bohn, L.; Schäfer, W.; et al. Identification of a Gene Cluster Responsible for the Biosynthesis of Aurofusarin in the Fusarium Graminearum Species Complex. Fungal Genet. Biol. 2005, 42, 420–433. [Google Scholar] [CrossRef]
- Frandsen, R.J.N.; Nielsen, N.J.; Maolanon, N.; Sorensen, J.C.; Olsson, S.; Nielsen, J.; Giese, H. The Biosynthetic Pathway for Aurofusarin in Fusarium Graminearum Reveals a Close Link between the Naphthoquinones and Naphthopyrones. Mol. Microbiol. 2006, 61, 1069–1080. [Google Scholar] [CrossRef]
- Frandsen, R.J.N.; Schütt, C.; Lund, B.W.; Staerk, D.; Nielsen, J.; Olsson, S.; Giese, H. Two Novel Classes of Enzymes Are Required for the Biosynthesis of Aurofusarin in Fusarium Graminearum. J. Biol. Chem. 2011, 286, 10419–10428. [Google Scholar] [CrossRef]
- Olsson, S. Uptake of Glucose and Phosphorus by Growing Colonies of Fusarium Oxysporum as Quantified by Image Analysis. Exp. Mycol. 1994, 18, 33–47. [Google Scholar] [CrossRef]
- Olsson, S. Mycelial Density Profiles of Fungi on Heterogeneous Media and Their Interpretation in Terms of Nutrient Reallocation Patterns. Mycol. Res. 1995, 99, 143–153. [Google Scholar] [CrossRef]
- Olsson, S. Colonial Growth of Fungi. In Biology of the Fungal Cell; Howard, R.J., Gow, N.A.R., Eds.; The Mycota; Springer: Berlin/Heidelberg, Germany, 2001; pp. 126–141. [Google Scholar]
- Ghodsalavi, B.; Svenningsen, N.B.; Hao, X.; Olsson, S.; Nicolaisen, M.H.; Al-Soud, W.A.; Sørensen, S.J.; Nybroe, O. A Novel Baiting Microcosm Approach Used to Identify the Bacterial Community Associated with Penicillium Bilaii Hyphae in Soil. PLoS ONE 2017, 12, e0187116. [Google Scholar] [CrossRef]
- Větrovský, T.; Baldrian, P. The Variability of the 16S RRNA Gene in Bacterial Genomes and Its Consequences for Bacterial Community Analyses. PLoS ONE 2013, 8, e57923. [Google Scholar] [CrossRef] [PubMed]
- Klappenbach, J.A.; Dunbar, J.M.; Schmidt, T.M. RRNA Operon Copy Number Reflects Ecological Strategies of Bacteria. Appl. Environ. Microbiol. 2000, 66, 1328–1333. [Google Scholar] [CrossRef] [PubMed]
- Josefsen, L.; Droce, A.; Sondergaard, T.E.; Sørensen, J.L.; Bormann, J.; Schäfer, W.; Giese, H.; Olsson, S. Autophagy Provides Nutrients for Nonassimilating Fungal Structures and Is Necessary for Plant Colonization but Not for Infection in the Necrotrophic Plant Pathogen Fusarium Graminearum. Autophagy 2012, 8, 326–337. [Google Scholar] [CrossRef]
- Oberhardt, M.A.; Zarecki, R.; Gronow, S.; Lang, E.; Klenk, H.-P.; Gophna, U.; Ruppin, E. Harnessing the Landscape of Microbial Culture Media to Predict New Organism–Media Pairings. Nat. Commun. 2015, 6, 8493. [Google Scholar] [CrossRef] [PubMed]
- Newman, E.I.; Watson, A. Microbial Abundance in the Rhizosphere: A Computer Model. Plant Soil 1977, 48, 17–56. [Google Scholar] [CrossRef]

| Primers | Sequence | |
|---|---|---|
| mCherry | PCB1532 F | GCAACCCAAGGGACCATCT |
| PCB1532 R | TTGACCTCAGCGTCGTAGTG | |
| 16SrRNA | 27 F | AGAGTTTGATCCTGGCTCAG |
| 1492 R | TACGGTACCTTGTTACGACTT | |
Publisher’s Note: MDPI stays neutral with regard to jurisdictional claims in published maps and institutional affiliations. |
© 2022 by the authors. Licensee MDPI, Basel, Switzerland. This article is an open access article distributed under the terms and conditions of the Creative Commons Attribution (CC BY) license (https://creativecommons.org/licenses/by/4.0/).
Share and Cite
Ali, H.; Pei, M.; Li, H.; Fang, W.; Mao, H.; Khan, H.A.; Nadeem, T.; Lu, G.; Olsson, S. The Wheat Head Blight Pathogen Fusarium graminearum Can Recruit Collaborating Bacteria from Soil. Cells 2022, 11, 3004. https://doi.org/10.3390/cells11193004
Ali H, Pei M, Li H, Fang W, Mao H, Khan HA, Nadeem T, Lu G, Olsson S. The Wheat Head Blight Pathogen Fusarium graminearum Can Recruit Collaborating Bacteria from Soil. Cells. 2022; 11(19):3004. https://doi.org/10.3390/cells11193004
Chicago/Turabian StyleAli, Hina, Mengtian Pei, Hongchen Li, Wenqin Fang, Hongkun Mao, Hamid Ali Khan, Tariq Nadeem, Guodong Lu, and Stefan Olsson. 2022. "The Wheat Head Blight Pathogen Fusarium graminearum Can Recruit Collaborating Bacteria from Soil" Cells 11, no. 19: 3004. https://doi.org/10.3390/cells11193004
APA StyleAli, H., Pei, M., Li, H., Fang, W., Mao, H., Khan, H. A., Nadeem, T., Lu, G., & Olsson, S. (2022). The Wheat Head Blight Pathogen Fusarium graminearum Can Recruit Collaborating Bacteria from Soil. Cells, 11(19), 3004. https://doi.org/10.3390/cells11193004

